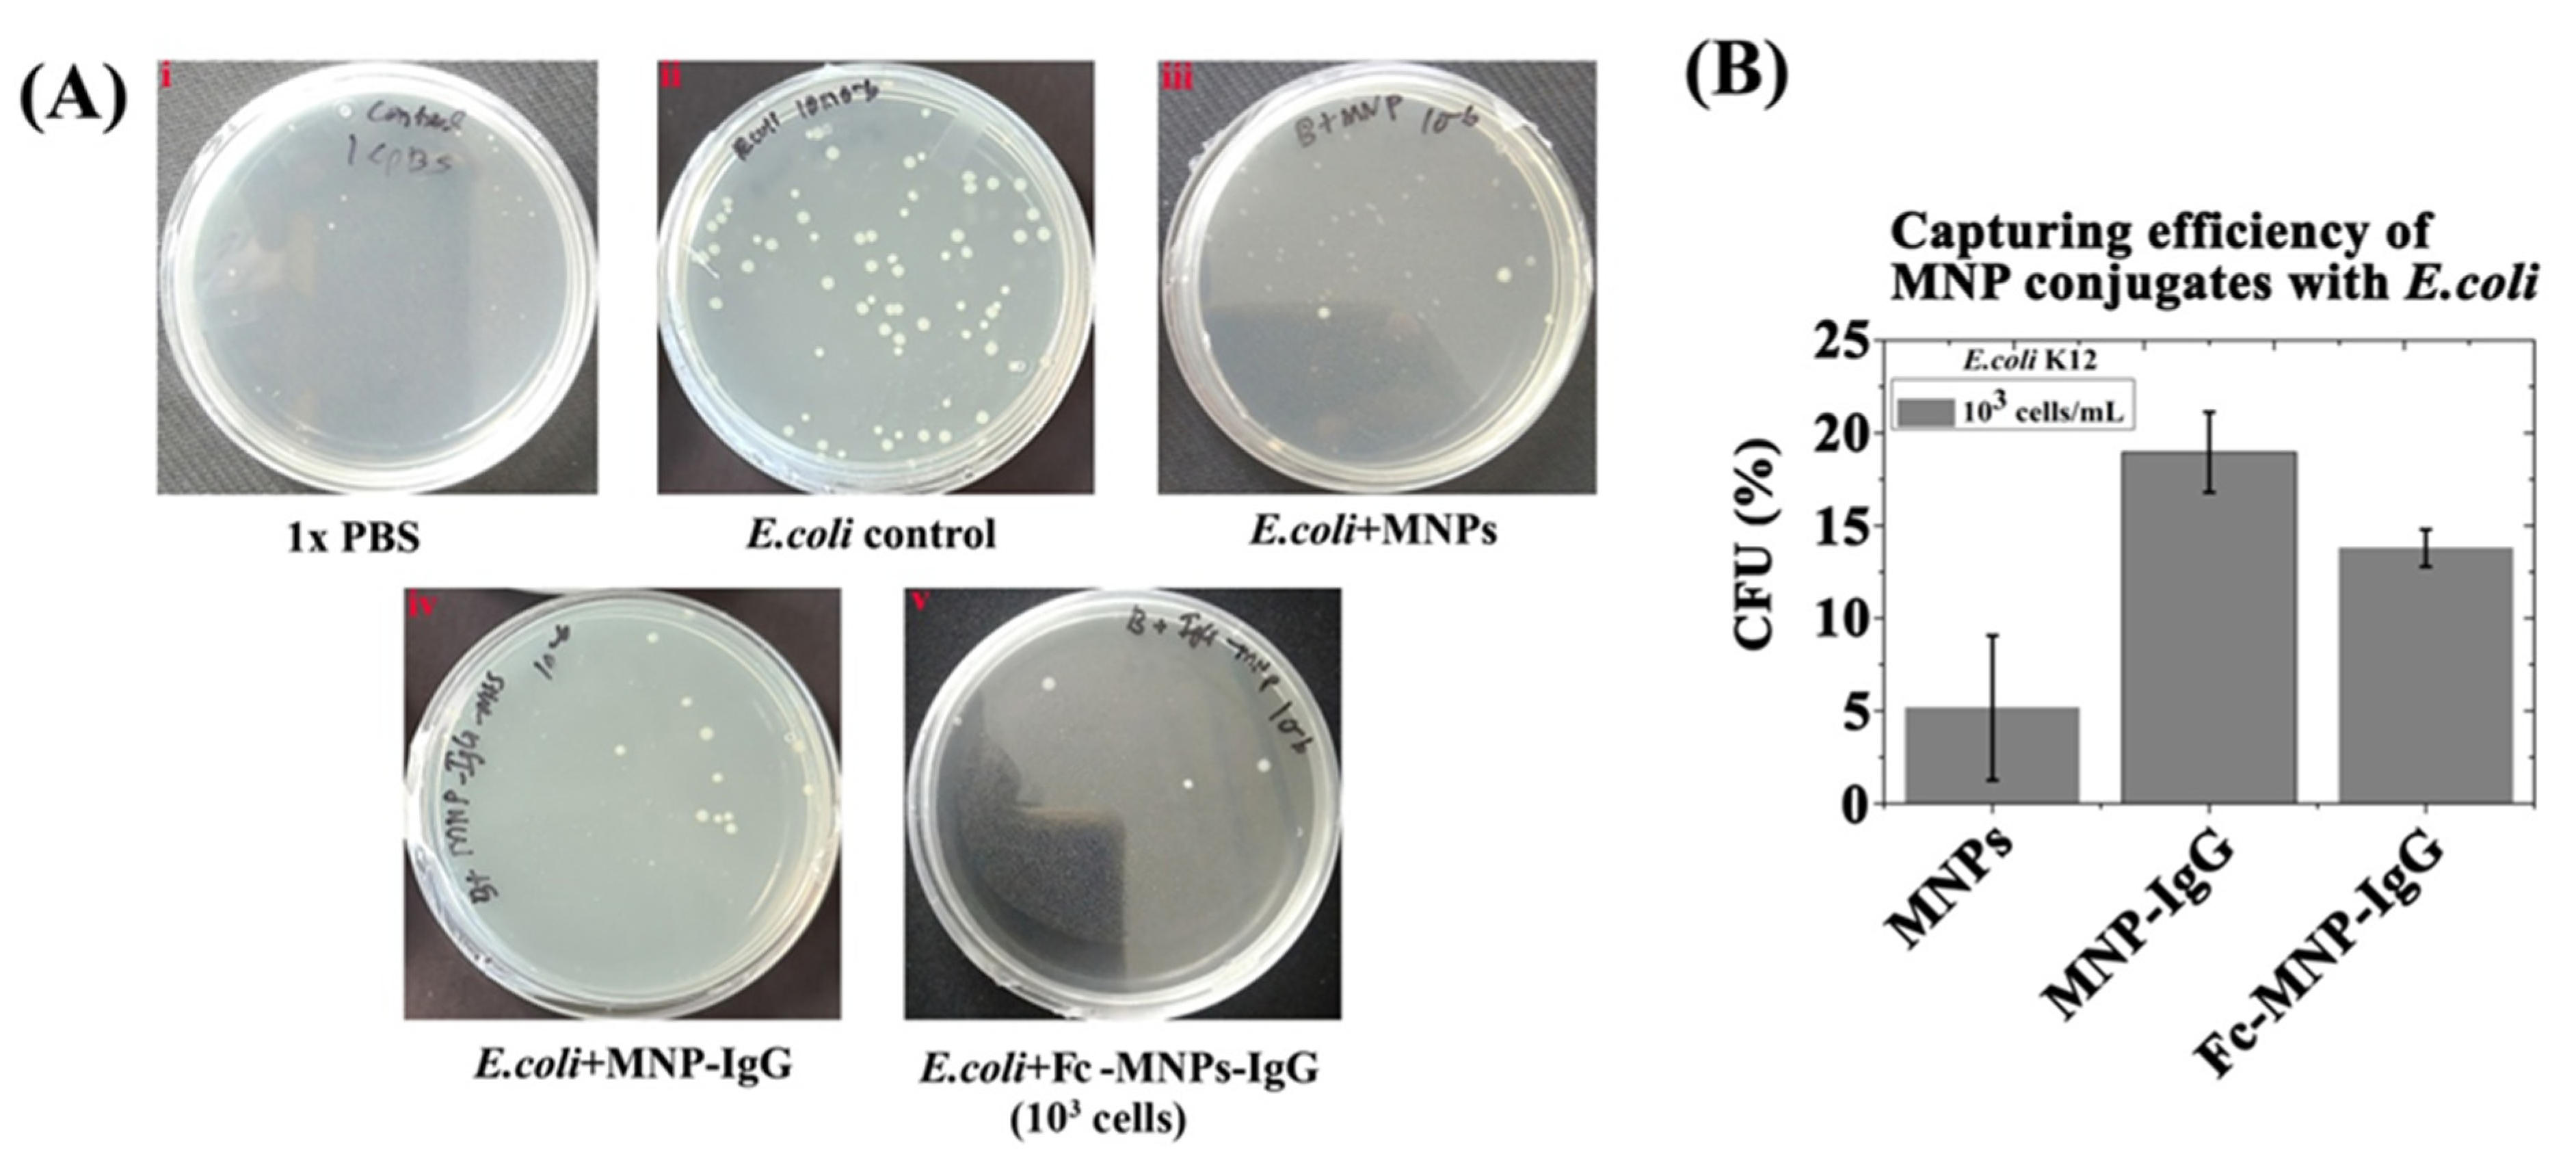
Biosensors 12 00036 g005 550

Electrochemical Detection of Waterborne Bacteria Using Bi-Functional Magnetic Nanoparticle Conjugates
Abstract
:1. Introduction
2. Materials and Methods
2.1. Preparation and Characterizations of Bi-Functional Magnetic Nanoparticles (Fc-MNP-IgG)
2.1.1. Preparation of Fc-MNP Conjugate
2.1.2. Preparation of IgG–MNP Conjugate
2.1.3. Preparation of Bi-Functional MNPs (Fc-MNP-IgG)
2.2. Investigation of Binding Efficiency of Mono and Bi-Functional MNP Conjugates to E. coli
2.3. Electrochemical Detection of E. coli Cells Using Bi-Functional MNP Conjugates (Fc-MNP-IgG) by SWV
2.4. Fc-MNP-IgG Specificity Analysis Using Different Bacterial Strains
3. Results
3.1. Preparation of Mono- and Bi-Functional MNP Conjugates
3.1.1. Preparation of Fc-MNP Conjugates
3.1.2. Preparation of IgG-MNP Conjugates
3.1.3. Preparation of Bi-Functional MNP Conjugate (Fc-MNP-IgG)
3.1.4. Characterization of MNPs Conjugates
3.2. The Binding Efficiency of Mono and Bi-Functional MNP Conjugates to E. coli
3.3. Electrochemical Analysis of MNPs Conjugates Binding Efficiency to E. coli
3.4. Effect of E. coli Cells Concentrations on Bi-Functional Fc-MNP-IgG Conjugates SW Voltammogram
3.5. Fc-MNP-IgG Specificity Analysis Using Different Bacterial Strains
3.6. Validation in Various Water Sources
4. Discussion
5. Conclusions
Supplementary Materials
Author Contributions
Funding
Institutional Review Board Statement
Informed Consent Statement
Data Availability Statement
Acknowledgments
Conflicts of Interest
References
- World Population Prospects: The 2019 Revision (XLS). Population Division of the Department of Economic and Social Affairs of the United Nations Secretariat. Available online: https://reliefweb.int/sites/reliefweb.int/files/resources/WPP2019_Highlights.pdf (accessed on 20 October 2021).
- UNESCO World Water Assessment Program. The United Nations World Water Development Report 2019: Leaving No One Behind. Available online: https://en.unesco.org/themes/water-security/wwap/wwdr/2019 (accessed on 20 October 2021).
- Sharma, S.; Bhattacharya, A. Drinking water contamination and treatment techniques. Appl. Water Sci. 2017, 7, 1043–1067. [Google Scholar] [CrossRef] [Green Version]
- Postigo, C.; Martinez, D.E.; Grondona, S.; Miglioranza, K.S.B. Groundwater Pollution: Sources, Mechanisms, and Prevention. Reference Module in Earth Systems and Environmental Sciences. In Encyclopedia of the, Anthropocene; Dellasala, A.D., Goldstein, M.I., Eds.; Elsevier: Amsterdam, The Netherlands, 2018; Volume 5, pp. 87–96. [Google Scholar]
- Pollio, V. The Ten Books on Architecture, Book II; Morgan, M.H., Ed.; Harvard University Press: Cambridge, UK; Milford, UK; Oxford University Press: London, UK, 1914; pp. 35–64. [Google Scholar]
- Vikesland, P.J. Nanosensors for water quality monitoring. Nat. Nanotechnol. 2018, 13, 651–660. [Google Scholar] [CrossRef] [PubMed]
- Marin, P.; Tal, S.; Yeres, J.; Ringskog, K. Water Management in Israel. World Bank Group. Available online: https://documents1.worldbank.org/curated/en/657531504204943236/pdf/Water-management-in-Israel-key-innovations-and-lessons-learned-for-water-scarce-countries.pdf (accessed on 20 October 2021).
- Rompre, A.; Servais, P.; Baudart, J.; de-Roubin, M.-R.; Laurent, P. Detection and enumeration of coliforms in drinking water: Current methods and emerging approaches. J. Microbiol. Methods 2002, 49, 31–54. [Google Scholar] [CrossRef]
- Alvarez, A.; Hernandez-Delgado, E.A.; Toranzos, G.A. Advantages and Disadvantages of Traditional and Molecular Techniques Applied to the Detection of Pathogens in Waters. Water Sci. Technol. 1993, 27, 253–256. [Google Scholar] [CrossRef]
- Va’radi, L.; Luo, J.L.; Hibbs, D.E.; Perry, J.D.; Anderson, R.J.; Orengae, S.; Groundwater, P.W. Methods for the detection and identification of pathogenic bacteria: Past, present, and future. Chem. Soc. Rev. 2017, 46, 4818–4832. [Google Scholar] [CrossRef]
- Palchetti, I. New trends in the design of enzyme-based biosensors for medical applications. Mini Rev. Med. Chem. 2016, 16, 1125–1133. [Google Scholar] [CrossRef]
- Liu, H.; Ge, J.; Ma, E.; Yang, L. Advanced biomaterials for biosensor and theranostics. Biomaterials in Translational Medicine. In A Biomaterials Approach Woodhead Publishing Series in Biomaterials; Academic Press: Cambridge, MA, USA, 2019; pp. 213–255. [Google Scholar]
- Varshney, M.; Yang, L.; Su, X.-L.; Li, Y. Magnetic Nanoparticle-Antibody Conjugates for the Separation of Escherichia Coli O157:H7 in Ground Beef. J. Food Prot. 2005, 68, 1804–1811. [Google Scholar] [CrossRef]
- Bari, M.L.; Kawasaki, S. Rapid Methods for Food Hygiene Inspection. In Encyclopedia of Food Microbiology; Batt, C.A., Tortorello, M.L., Eds.; Academic Press: Cambridge, MA, USA, 2014; Volume 3, pp. 269–279. [Google Scholar]
- Chu, Y.W.; Engebretson, D.A.; Carey, J.R. Bioconjugated magnetic nanoparticles for the detection of bacteria. J. Biomed. Nanotechnol. 2013, 9, 1951–1961. [Google Scholar] [CrossRef]
- Augustine, R.; Abraham, A.R.; Kalarikkal, N.; Thomas, S. Monitoring and separation of food-borne pathogens using magnetic nanoparticles. In Novel Approaches of Nanotechnology in Food, Nanotechnology in the Agri-Food Industry; Academic Press: Cambridge, MA, USA, 2016; Volume 1, pp. 271–312. [Google Scholar]
- The’venot, D.R.; Toth, K.; Durst, R.A.; Wilson, G.S. Technical report Electrochemical biosensors: Recommended definitions and classification. Biosens. Bioelectron. 2001, 16, 121–131. [Google Scholar]
- Singh, P.; Pandey, S.K.; Singh, J.; Srivastava, S.; Sachan, S.; Singh, S.K. Biomedical Perspective of Electro-chemical Nanobiosensor. Nano-Micro Lett. 2016, 8, 193–203. [Google Scholar] [CrossRef] [Green Version]
- Grieshaber, D.; MacKenzie, R.; Vörös, J.; Reimhult, E. Electrochemical Biosensors-Sensor Principles and Architectures. Sensors 2008, 8, 1400–1458. [Google Scholar] [CrossRef]
- Wu, J.; Ju, H.X. Clinical Immunoassays and Immunosensing. Reference Module in Chemistry, Molecular Sciences and Chemical Engineering. Comprehensive Sampling and Sample Preparation. Analytical Techniques for Scientists; Elsevier: Amsterdam, The Netherlands, 2012; Volume 3, pp. 143–167. [Google Scholar]
- Sharma, A.; Rao, V.K.; Kamboj, D.V.; Gaur, R.; Shaik, M.; Shrivastava, A.R. Enzyme free detection of staphylococcal enterotoxin B (SEB) using ferrocene carboxylic acid labeled monoclonal antibodies: An electro-chemical approach. New J. Chem. 2016, 40, 8334–8341. [Google Scholar] [CrossRef]
- Michael Immanuel Jesse, D.; Sukanya, R.; Nallusamy, D.; Raja Muthuramalingam, T.; Mohammed Riyaz, S.U.; Dharanivasan, G.; Kathiravan, K. Preparation, characterization and application of antibody-conjugated magnetic nanoparticles in the purification of begomovirus. RSC Adv. 2015, 5, 99820–99831. [Google Scholar]
- Cai, G.; Wang, S.; Zheng, L.; Lin, J. A Fluidic Device for Immunomagnetic Separation of Foodborne Bacteria Using Self-Assembled Magnetic Nanoparticle Chains. Micromachines 2018, 624, 624. [Google Scholar] [CrossRef] [Green Version]
- Okochi, M.; Ohta, H.; Tanaka, T.; Matsunaga, T. Electrochemical probe for on-chip type flow immunoassay: Immunoglobulin G labeled with ferrocenecarboaldehyde. Biotechnol. Bioeng. 2005, 90, 14–19. [Google Scholar] [CrossRef]
- Fabbrizzi, L. The ferrocenium/ferrocene couple: A versatile redox switch. ChemTexts 2020, 6, 1–20. [Google Scholar] [CrossRef]
- World Health Organization. Available online: https://www.who.int/news/item/18-06-2019-1-in-3-people-globally-do-not-have-access-to-safe-drinking-water-unicef-who (accessed on 20 October 2021).
- Canciu, A.; Tertis, M.; Hosu, O.; Cernat, A.; Cristea, C.; Graur, F. Modern Analytical Techniques for Detection of Bacteria in Surface and Wastewaters. Sustainability 2021, 13, 7229. [Google Scholar] [CrossRef]
- Mishra, G.K.; Barfidokht, A.; Tehrani, F.; Mishra, R.K. Food Safety Analysis Using Electrochemical Bio-sensors. Foods 2018, 7, 141. [Google Scholar] [CrossRef] [PubMed] [Green Version]
- Menon, S.; Mathew, M.R.; Sam, S.; Keerthi, K.; Kumar, K.G. Recent advances and challenges in electrochemical biosensors for emergingand re-emerging infectious diseases. J. Electroanal. Chem. 2020, 878, 1145962. [Google Scholar] [CrossRef] [PubMed]
- Wang, J. Portable electrochemical systems. TrAC Trend. Anal. Chem. 2002, 21, 226–232. [Google Scholar] [CrossRef]
- Li, D.; Feng, Y.; Zhou, L.; Ye, Z.; Wang, J.; Ying, Y.; Ruan, C.; Wang, R.; Li, Y. Label-free capacitive immunosensor based on quartz crystal Au electrode for rapid and sensitive detection of Escherichia Coli O157:H7. Anal. Chim. Acta 2011, 687, 89–96. [Google Scholar] [CrossRef]
- Abraham, O.O.; Idan, A.; Itzik, I.; Orr, H.S.; Sefi Vernick. Rapid detection and quantification of microcystins in surface water by an impedimetric immunosensor. Sens. Actuators B Chem. 2021, 348, 130687. [Google Scholar]
- Oh, Y.; Heien, M.L.; Park, C.; Kang, Y.M.; Kim, J.; Boschen, S.L.; Shin, H.; Cho, H.U.; Blaha, C.D.; Bennet, K.E.; et al. Tracking tonic dopamine levels in vivo using multiple cyclic square wave voltammetry. Biosens. Bioelectron. 2018, 121, 174–182. [Google Scholar] [CrossRef]
- Verma, S.K.; Thirumurugan, A.; Panda, P.K.; Patel, P.; Nandi, A.; Jha, E.; Prabakaran, K.; Udayabhaskar, R.; Mangalaraja, R.V.; Mishra, Y.K.; et al. Altered electrochemical properties of iron oxide nanoparticles by carbonenhance molecular biocompatibility through discrepant atomic interaction. Mater. Today Bio 2021, 12, 100131. [Google Scholar] [CrossRef] [PubMed]
- Kumar, M.R.A.; Abebe, B.; Nagaswarupa, H.P.; Ananda Murthy, H.C.; Ravikumar, C.R.; Sabir, F.K. Enhanced photocatalytic and electrochemical performance of TiO2-Fe2O3 nanocomposite: Its applications in dye decolorization and as supercapacitors. Sci. Rep. 2020, 10, 1249. [Google Scholar] [CrossRef] [PubMed] [Green Version]
- Cao, D.; He, P.; Hu, N. Electrochemical biosensors utilising electron transfer in heme proteins immobilised on Fe3O4 nanoparticles. Analyst 2003, 128, 1268–1274. [Google Scholar] [CrossRef]
- Setterington, E.B.; Alocilja, E.C. Electrochemical Biosensor for Rapid and Sensitive Detection of Magneti-cally Extracted Bacterial Pathogens. Biosensors 2012, 2, 15–31. [Google Scholar] [CrossRef] [Green Version]
- Saha, B.; Evers, T.H.; Prins, M.W.J. How antibody surface coverage on nanoparticles determines the activity and kinetics of antigen capturing for biosensing. Anal. Chem. 2014, 86, 8158–8166. [Google Scholar] [CrossRef] [Green Version]
- Sulaiman, G.M.; Tawfeeq, A.T.; Naji, A.S. Biosynthesis, characterization of magnetic iron oxide nanoparticles and evaluations of the cytotoxicity and DNA damage of human breast carcinoma cell lines. Artif. Cells Nanomed. Biotechnol. 2018, 4, 1215–1229. [Google Scholar] [CrossRef]
- Wu, H.; Teng, C.; Tian, H.; Li, Y.; Wang, J. Fabrication of functional magnetic cellulose nanocomposite membranes for controlled adsorption of protein. Cellulose 2018, 25, 2977–2986. [Google Scholar] [CrossRef]
- Rajeev, G.; Cowin, A.J.; Voelcker, N.H.; Prieto Simon, B. Magnetic nanoparticles enhance Pore blockage-based electrochemical detection of a wound biomarker. Front. Chem. 2019, 7, 438. [Google Scholar] [CrossRef] [Green Version]
- Anghelache, M.; Turtoi, M.; Petrovici, A.R.; Fifere, A.; Pinteala, M.; Calin, M. Development of dextran-coated magnetic nanoparticles loaded with protocatechuic acid for vascular inflammation therapy. Pharmaceutics 2021, 13, 1414. [Google Scholar] [CrossRef]
- Haghighi, A.H.; Khorasani, M.T.; Faghih, Z.; Farjadian, F. Effects of different quantities of antibody conjugated with magnetic nanoparticles on cell separation efficiency. Heliyon 2020, 6, e03677. [Google Scholar] [CrossRef]
- Xu, H.; Tang, F.; Dai, J.; Wang, C.; Zhou, X. Ultrasensitive and rapid count of Escherichia Coli using magnetic nanoparticle probe under dark-field microscope. BMC Microbiol. 2018, 18, 100. [Google Scholar] [CrossRef] [Green Version]
- Mbaba, M.; Mabhula, A.N.; Boel, N.; Edkins, A.L.; Isaacs, M.; Hoppe, H.C.; Khanye, S.D. Ferrocenyl and organic novobiocin derivatives: Synthesis and their in vitro biological activity. J. Inorg. Biochem. 2017, 172, 88–93. [Google Scholar] [CrossRef] [PubMed]
- Costa, N.C.S.; Piccoli, J.P.; Santos-Filho, N.A.; Clementino, L.C.; Fusco-Almeida, A.M.; De Annunzio, S.R.; Fontana, C.R.; Verga, J.B.; Eto, S.F.; Pizauro-Junior, J.M.; et al. Antimicrobial Activity of RP-1 Peptide Conjugate with Ferrocene Group. PLoS ONE 2020, 15, e0228740. [Google Scholar] [CrossRef] [Green Version]
- Luciani, M.; Di Febo, T.; Zilli, K.; Di Giannatale, E.; Armillotta, G.; Manna, L.; Minelli, F.; Tittarelli, M.; Caprioli, A. Rapid detection and isolation of escherichia coli O104:H4 from milk using monoclonal antibody-coated magnetic beads. Front. Microbiol. 2016, 7, 942. [Google Scholar] [CrossRef] [PubMed] [Green Version]
- Shen, Z.; Hou, N.; Jin, M.; Qiu, Z.; Wang, J.; Zhang, B.; Wang, X.; Wang, J.; Zhou, D.; Li, J. A novel enzyme-linked immunosorbent assay for detection of Escherichia Coli O157:H7 using immunomagnetic and beacon gold nanoparticles. Gut Pathog. 2014, 6, 1–8. [Google Scholar] [CrossRef] [PubMed] [Green Version]
- Kromann, S.; Kudirkiene, E.; Li, L.; Thoefner, I.; Daldorph, E.; Christensen, J.P.; Meng, H.; Olsen, R.H. Treatment with high-dose antidepressants severely exacerbates the pathological outcome of experimental Escherichia Coli infections in poultry. PLoS ONE 2017, 12, e0185914. [Google Scholar] [CrossRef] [Green Version]
- Nanninga, N. Morphogenesis of Escherichia Coli. Microbiol. Mol. Biol. Rev. 1998, 62, 110–129. [Google Scholar] [CrossRef] [Green Version]
- Prats, R.; de Pedro, M.A. Normal Growth and Division of Escherichia Coli with a Reduced Amount of Murein. J. Bacteriol. 1989, 171, 3740–3745. [Google Scholar] [CrossRef] [PubMed] [Green Version]

Publisher’s Note: MDPI stays neutral with regard to jurisdictional claims in published maps and institutional affiliations. |
© 2022 by the authors. Licensee MDPI, Basel, Switzerland. This article is an open access article distributed under the terms and conditions of the Creative Commons Attribution (CC BY) license (https://creativecommons.org/licenses/by/4.0/).
Share and Cite
Gunasekaran, D.; Gerchman, Y.; Vernick, S. Electrochemical Detection of Waterborne Bacteria Using Bi-Functional Magnetic Nanoparticle Conjugates. Biosensors 2022, 12, 36. https://doi.org/10.3390/bios12010036
Gunasekaran D, Gerchman Y, Vernick S. Electrochemical Detection of Waterborne Bacteria Using Bi-Functional Magnetic Nanoparticle Conjugates. Biosensors. 2022; 12(1):36. https://doi.org/10.3390/bios12010036
Chicago/Turabian StyleGunasekaran, Dharanivasan, Yoram Gerchman, and Sefi Vernick. 2022. "Electrochemical Detection of Waterborne Bacteria Using Bi-Functional Magnetic Nanoparticle Conjugates" Biosensors 12, no. 1: 36. https://doi.org/10.3390/bios12010036
APA StyleGunasekaran, D., Gerchman, Y., & Vernick, S. (2022). Electrochemical Detection of Waterborne Bacteria Using Bi-Functional Magnetic Nanoparticle Conjugates. Biosensors, 12(1), 36. https://doi.org/10.3390/bios12010036

